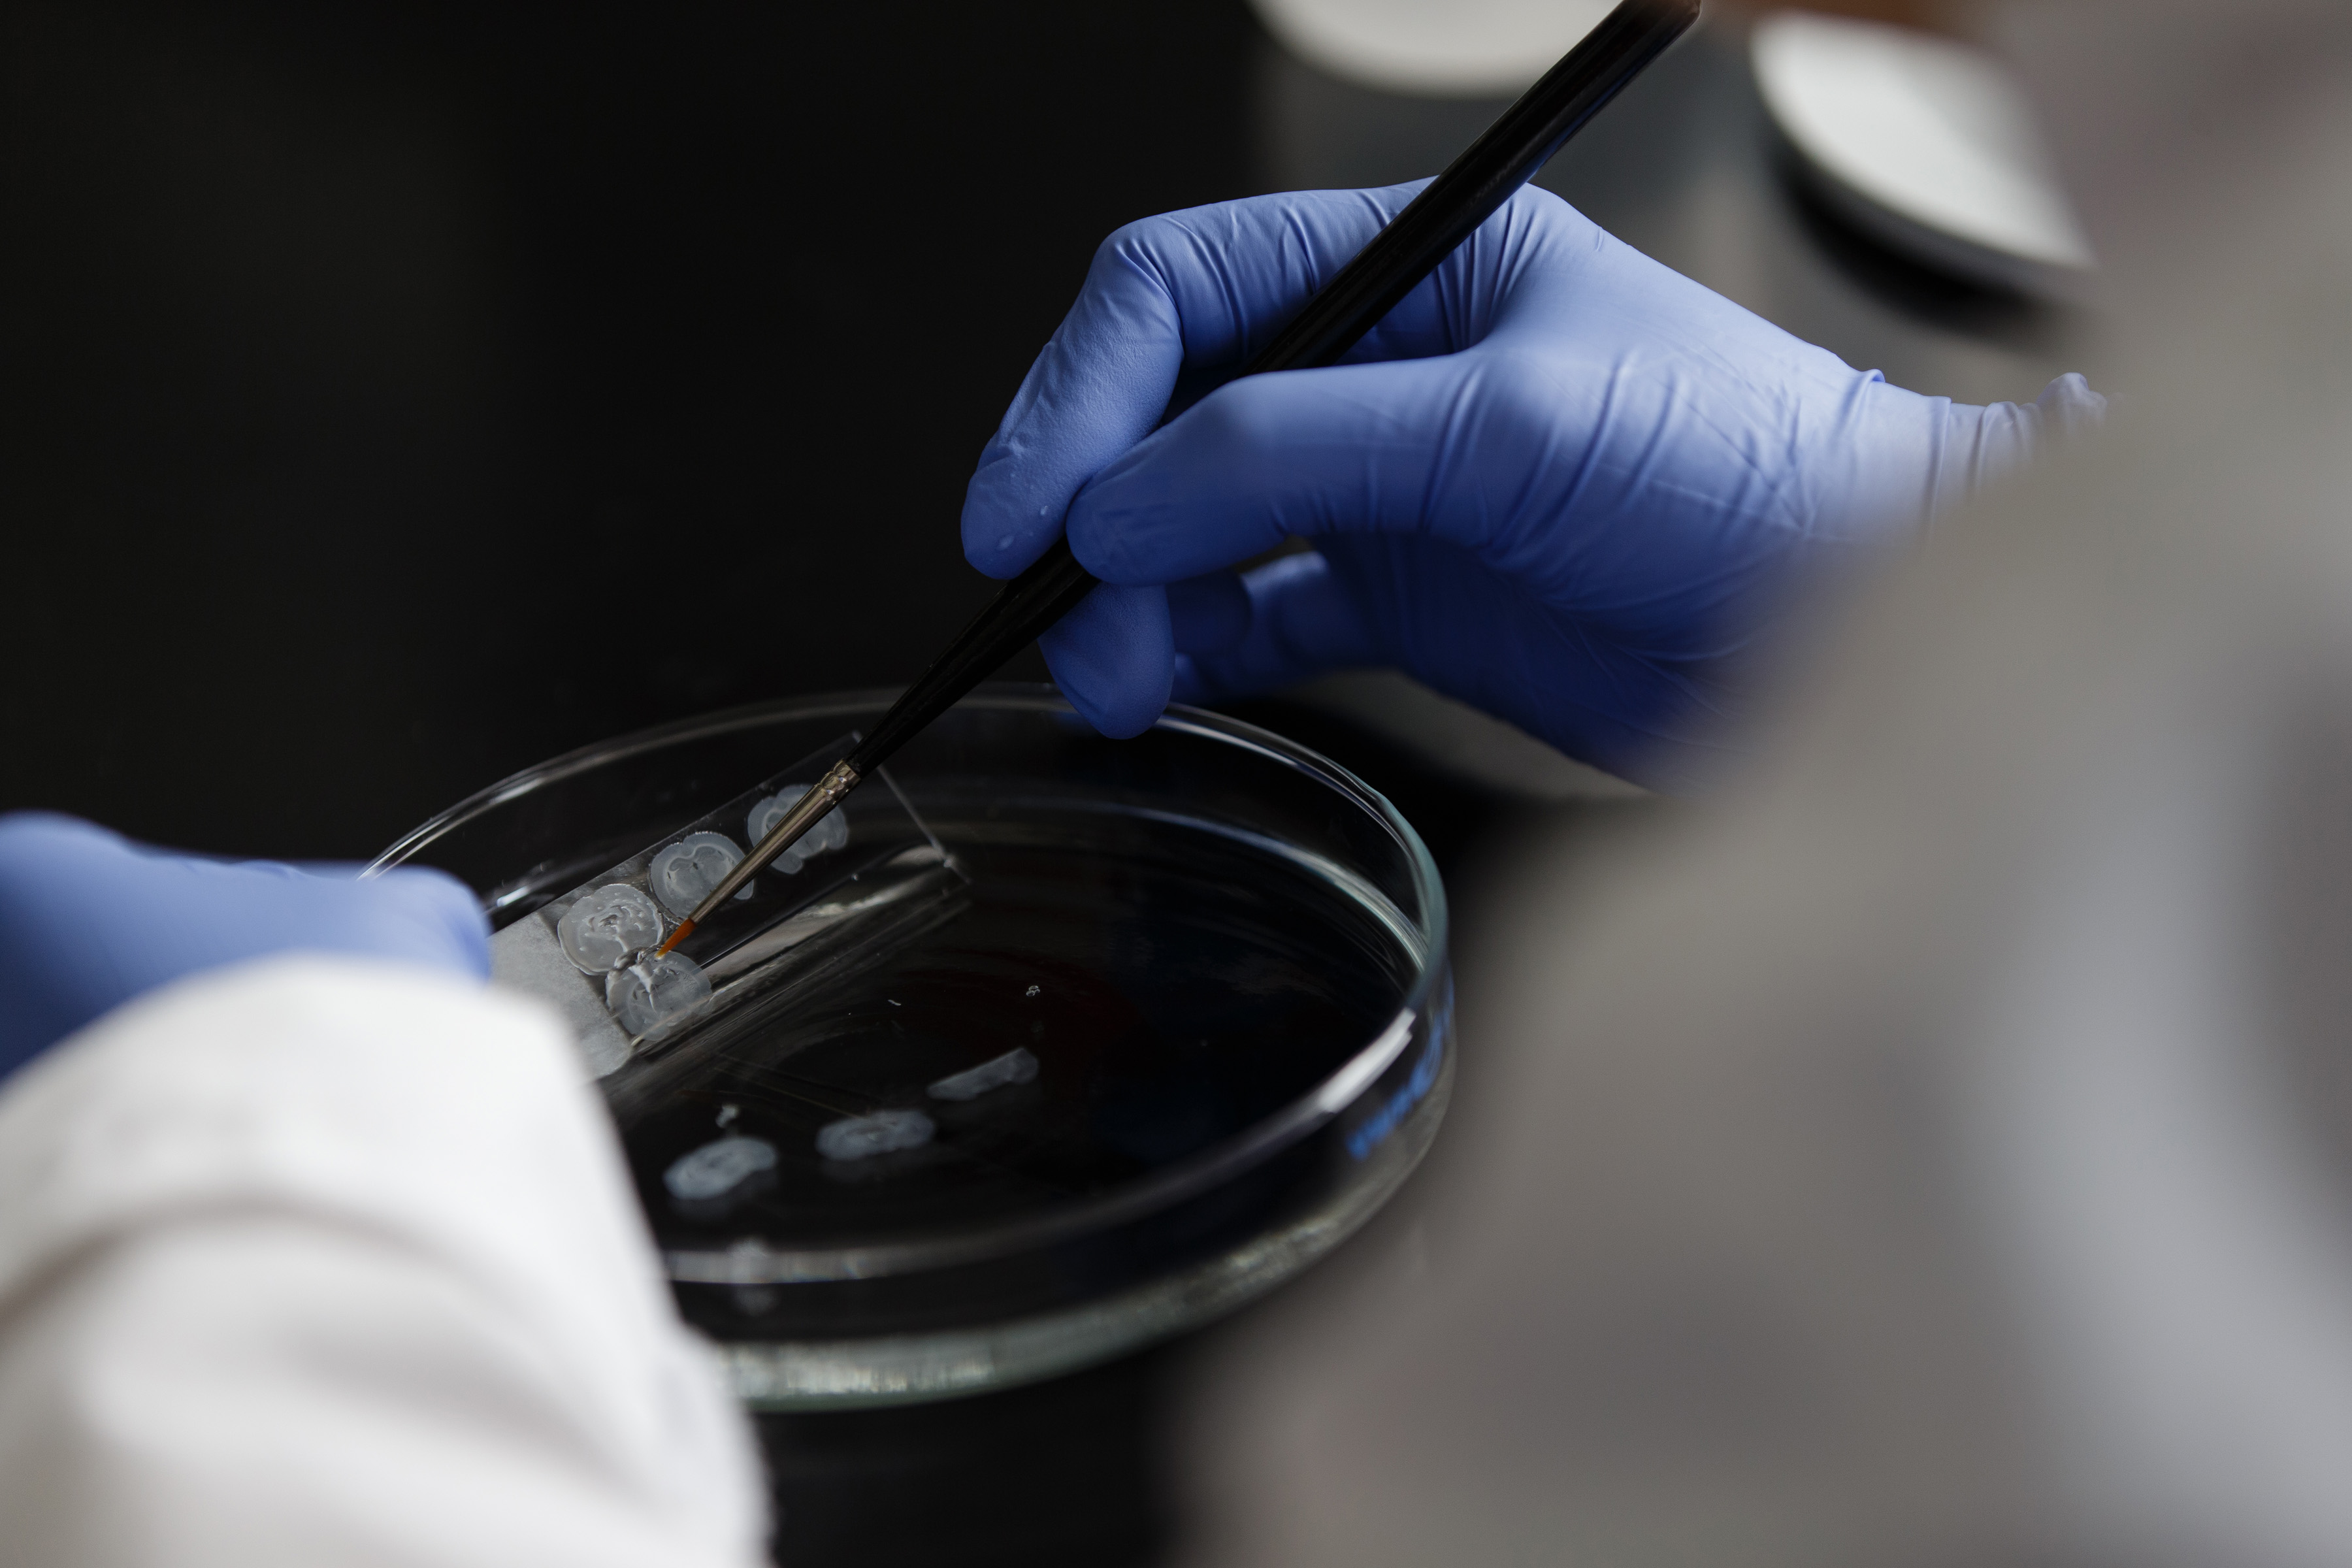

Contextual Control of Extinction
Extinction-based therapies, such as prolonged exposure, are used to reduce fear in patients with fear and anxiety disorders. Unfortunately, the loss of fear that occurs during extinction is often limited to the extinction context and vulnerable to relapse. We are mapping the neural circuits involved in extinction memory and fear relapse. We focus on connections between the hippocampus, amygdala, and prefrontal cortex. A recent focus has been on the role of the nucleus reuniens, which interconnects the hippocampus and medial prefrontal cortex, in extinction acquisition and retrieval. This project is funded by a the NIH (R01MH065961). Recent paper: Marek et al. (2018). Hippocampus-dependent feed-forward inhibition of the prefrontal cortex mediates relapse of extinguished fear. Nat. Neurosci., 21(3):384-392.

Stress and Extinction Learning
Patients with post-traumatic stress disorder (PTSD) are resistant to extinction. This undermines therapy, because it makes PTSD patients vulnerable to relapse. We have discovered that extinction learning is impaired when it occurs soon after trauma resulting in an “immediate extinction deficit”. We have found that locus coeruleus norepinephrine (LC-NE) released in the amygdala suppresses prefrontal cortical circuits involved in extinction learning. This project is funded by the NIH grant (R01MH117852). Recent paper: Giustino et al. (2020). Locus coeruleus norepinephrine dives stress-induced increases in basolateral amygdala firing and impairs extinction learning. J. Neurosci., 40(4):907-916.






Covert Capture of Fear Memory
Extinction does not erase fear memories, and this leads to relapse. What if traumatic memories could be erased? We are using activity-dependent viral approaches to capture neuronal ensembles representing fear memories with the hopes of manipulating, even erasing, those memories. To this end, we have developed a behavioral procedure to covertly retrieve hippocampal-dependent context memories. This project was supported by a Distinguished Investigator Grant from the Brain and Behavior Research Foundation. Recent paper: Ressler at al., (2021). Covert capture and attenuation of a hippocampus-dependent fear memory. Nature Neuroscience, online.




Journal Covers





